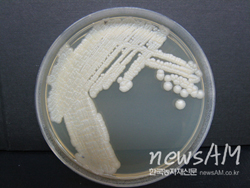

철저한 검증 통해 조합원에게 더 많은 이익과 시장경쟁력 향상
1998년 설립된 경기도작물보호제판매업협동조합 (이사장 고종원. 이하 경기작물보호제 판매조합)은 서울·인천·경기 등 다양한 작물이 재배되고 있는 수도권 지역에 위치해 취급하는 농자재 또한 다양하다. 특히 도시농업이 발달해 있어 소포장 농자재와 상토, 육묘용 트레이, 농업용 필름 등 도시농업에 필요한 농자재 수요도 높은 편이다. 고종원 이사장은 “경기작물보호제판매조합은 다른 지역 판매조합에 비해 농업지역보다는 도시지역이 많이 분포해 있어 도시농업에 대한 수요가 많다”며 “특히 아직도 도시화가 진행되고 있는 한편, 스마트팜 등 최첨단 농업시설 또한 증가하고 있어 도시농업 관련 수요는 늘어날 것으로 예측된다”고 말했다. 이어 “경기작물보호제판매조합은 지역 수요에 맞는 제품을 먼저 발굴하고 유통함으로써 조합원의 경쟁력을 높이고 지속가능한 사업을 영위하는 데 도움이 되도록 최선을 다하고 있다”고 덧붙였다. 경기작물보호제판매조합은 고종원 이사장과 강승완 상무를 비롯한 6명의 임직원과 74명의 조합원이 약 330억 원의 매출을 올리고 있다. 특히 고종원 이사장은 2020년 제8대 이사장으로 취임 후 매출 성장과 실천하는 리더쉽으로 조합원은 물론 협력업체와도 신뢰 관계를